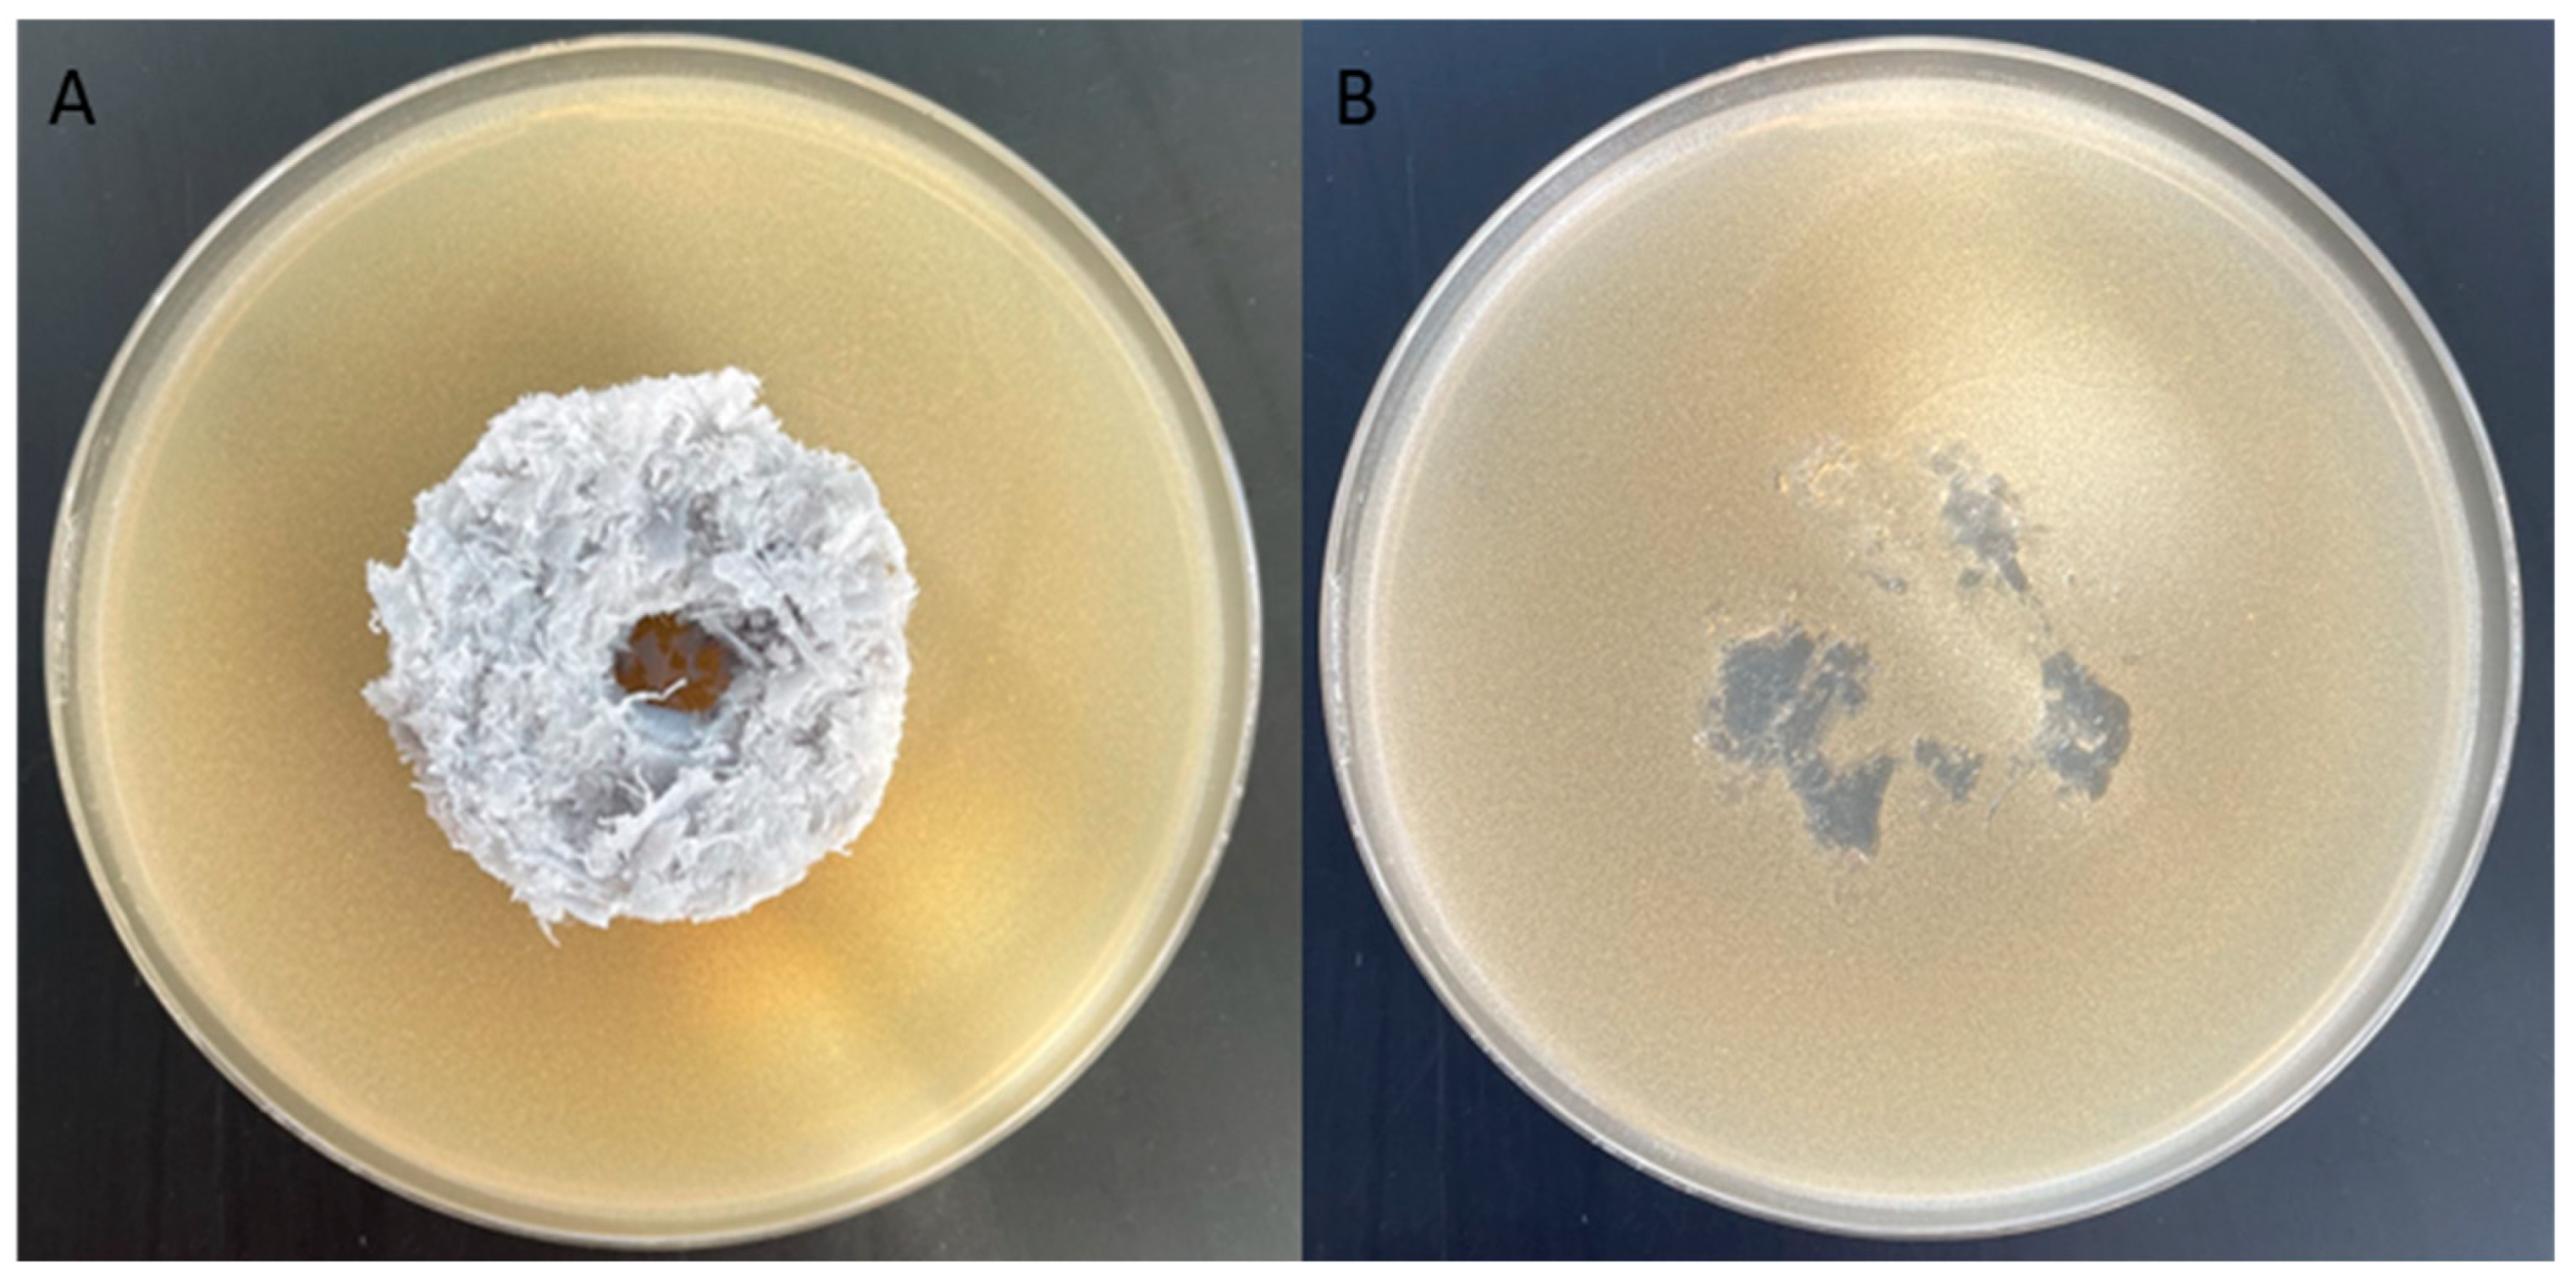

Assessment of Potential Use of a Composite Based on Polyester Textile Waste as Packing Elements of a Trickle Bed Bioreactor
Abstract
1. Introduction
2. Materials and Methods
2.1. Materials
2.2. Procedure for Preparing Packing Elements
2.3. Durability of Packing Elements
- mw—mass of the soaked element;
- md—weight of the dry element;
- V—volume of the dry element.
- mPM—mass of packing elements placed in the bioreactor;
- VPM—volume of packing elements placed in the bioreactor.
2.4. Microbicidal Properties of Packing Elements
2.5. Surface Properties of Packing Elements
2.6. Assessment of Adsorption of Copper (Cu) Ions by Packing Elements
2.7. Characteristics of the Treatment System
- -
- Reactor 1—elements made of polyester textile waste, 340 pieces weighing 2674.75 g;
- -
- Reactor 2—elements made of polyester textile waste, 340 pieces weighing 2672.05 g;
- -
- Reactor 3—elements of natural origin (LECA®), approx. 25 L of lightweight expanded clay aggregates weighing 3695.3 g.
2.8. Methods for the Analysis of Wastewater Composition
- COD1—chemical oxygen demand at the beginning of the cycle [mg/LO2];
- COD2—chemical oxygen demand at the end of the cycle [mg/LO2].
3. Results and Discussion
3.1. Characteristics of Materials Used for Packing Elements
- Burning tests: the fibres were burned and melted, forming a slowly cooling mass. After cooling, they formed a ball;
- Solubility tests in chemical reagents: fibres were dissolved in phenol at 75 °C;
- Observation under anoptical microscope: fibres mostly dull with lots of dark spots (Figure 3).
3.2. Characteristics of Packing Elements—Durability
3.3. Exclusion of Microbicidal Properties of the Element
- bacteria: Staphylococcus aureus and Escherichia coli;
- fungi: Aspergillus niger and Chaetomium globosum.
3.4. Characteristics of Packing Element Surface
3.5. Assessment of the Potential of Packing Elements Based on Textile Waste as a Substrate for Biofilm Formation
4. Conclusions
Author Contributions
Funding
Institutional Review Board Statement
Informed Consent Statement
Data Availability Statement
Acknowledgments
Conflicts of Interest
References
- Anand, A.; Unnikrishnan, B.; Mao, J.-Y.; Lin, H.-J.; Huang, C.-C. Graphene-Based Nanofiltration Membranes for Improving Salt Rejection, Water Flux and Antifouling—A Review. Desalination 2018, 429, 119–133. [Google Scholar] [CrossRef]
- Qadir, M.; Drechsel, P.; Jiménez Cisneros, B.; Kim, Y.; Pramanik, A.; Mehta, P.; Olaniyan, O. Global and Regional Potential of Wastewater as a Water, Nutrient and Energy Source. In Natural Resources Forum; Blackwell Publishing Ltd.: Oxford, UK, 2020; Volume 44, pp. 40–51. [Google Scholar] [CrossRef]
- Puchongkawarin, C.; Gomez-Mont, C.; Stuckey, D.C.; Chachuat, B. Optimization-Based Methodology for the Development of Wastewater Facilities for Energy and Nutrient Recovery. Chemosphere 2015, 140, 150–158. [Google Scholar] [CrossRef] [PubMed]
- Kundu, D.; Sharma, P.; Bhattacharya, S.; Gupta, K.; Sengupta, S.; Shang, J. Study of Methylene Blue Dye Removal Using Biochar Derived from Leaf and Stem of Lantana camara L. Carbon Res. 2024, 3, 22. [Google Scholar] [CrossRef]
- Sarayu, K.; Sandhya, S. Current Technologies for Biological Treatment of Textile Wastewater—A Review. Appl. Biochem. Biotechnol. 2012, 167, 645–661. [Google Scholar] [CrossRef] [PubMed]
- Date, M.; Jaspal, D. Dyes and Heavy Metals: Removal, Recovery and Wastewater Reuse—A Review. Sustain. Water Resour. Manag. 2024, 10, 90. [Google Scholar] [CrossRef]
- Katheresan, V.; Kansedo, J.; Lau, S.Y. Efficiency of Various Recent Wastewater Dye Removal Methods: A Review. J. Environ. Chem. Eng. 2018, 6, 4676–4697. [Google Scholar] [CrossRef]
- Da̧browski, A.; Hubicki, Z.; Podkościelny, P.; Robens, E. Selective Removal of the Heavy Metal Ions from Waters and Industrial Wastewaters by Ion-Exchange Method. Chemosphere 2004, 56, 91–106. [Google Scholar] [CrossRef] [PubMed]
- Olak-Kucharczyk, M.; Festinger, N.; Smułek, W. Application of Ozonation-Biodegradation Hybrid System for Polycyclic Aromatic Hydrocarbons Degradation. Int. J. Environ. Res. Public Health 2023, 20, 5347. [Google Scholar] [CrossRef]
- Zeinali Heris, S.; Etemadi, M.; Mousavi, S.B.; Mohammadpourfard, M.; Ramavandi, B. Preparation and Characterizations of TiO2/ZnO Nanohybrid and Its Application in Photocatalytic Degradation of Tetracycline in Wastewater. J. Photochem. Photobiol. A Chem. 2023, 443, 114893. [Google Scholar] [CrossRef]
- Abdelfattah, A.; Hossain, M.I.; Cheng, L. High-Strength Wastewater Treatment Using Microbial Biofilm Reactor: A Critical Review. World J. Microbiol. Biotechnol. 2020, 36, 75. [Google Scholar] [CrossRef]
- Ashrafivala, M.; Mousavi, S.B.; Zeinali Heris, S.; Heidari, M.; Mohammadpourfard, M.; Aslani, H. Investigation of H2O2/UV Advanced Oxidation Process on the Removal Rate of Coliforms from the Industrial Effluent: A Pilot-Scale Study. Int. J. Hydrogen Energy 2022, 47, 33530–33540. [Google Scholar] [CrossRef]
- Aguiar, G.J.A.; Almeida, L.R.; Fernandes, B.S.; Gavazza, S.; Silva, G.L.; Machado Santos, S. Use of Life Cycle Assessment as a Tool to Evaluate the Environmental Impacts of Textile Effluents: A Systematic Review. Environ. Sci. Pollut. Res. 2023, 30, 76455–76470. [Google Scholar] [CrossRef]
- Dicuonzo, G.; Galeone, G.; Ranaldo, S.; Turco, M. The Key Drivers of Born-Sustainable Businesses: Evidence from the Italian Fashion Industry. Sustainability 2020, 12, 10237. [Google Scholar] [CrossRef]
- Ahsan, A.; Jamil, F.; Rashad, M.; Hussain, M.; Inayat, A.; Akhter, P.; Al-Muhtaseb, A.; Lin, K.-Y.; Park, Y. Wastewater from the Textile Industry: Review of the Technologies for Wastewater Treatment and Reuse. Korean J. Chem. Eng. 2023, 40, 2060–2081. [Google Scholar] [CrossRef]
- Azanaw, A.; Birlie, B.; Teshome, B.; Jemberie, M. Textile Effluent Treatment Methods and Eco-Friendly Resolution of Textile Wastewater. Case Stud. Chem. Environ. Eng. 2022, 6, 100230. [Google Scholar] [CrossRef]
- Deckers, J.; Manshoven, S.; Mortensen, F.L. ETC/CE Report 2023/5 The Role of Bio-Based Textile Fibres in a Circular and Sustainable Textiles System. 2023. Available online: https://www.eionet.europa.eu/etcs/etc-ce/products/etc-ce-report-2023-5-the-role-of-bio-based-textile-fibres-in-a-circular-and-sustainable-textiles-system (accessed on 23 October 2023).
- Ellouze, E.; Tahri, N.; Amar, R. Ben Enhancement of Textile Wastewater Treatment Process Using Nanofiltration. Desalination 2012, 286, 16–23. [Google Scholar] [CrossRef]
- Jędrzejczak, M.; Wojciechowski, K. Skuteczność Oczyszczania Ścieków Farbiarskich. Chemik 2016, 70, 150–157. [Google Scholar]
- Cłapa, T.; Selwet, M.; Narożna, D. Życie w Społeczności-Warunki Powstawania Biofilmu. Kosm. Probl. Nauk Biol. 2016, 65, 463–468. [Google Scholar]
- Paździor, K.; Wrębiak, J.; Klepacz-Smółka, A.; Gmurek, M.; Bilińska, L.; Kos, L.; Sójka-Ledakowicz, J.; Ledakowicz, S. Influence of Ozonation and Biodegradation on Toxicity of Industrial Textile Wastewater. J. Environ. Manag. 2017, 195, 166–173. [Google Scholar] [CrossRef]
- Romanowska-Duda, Z. Metale Ciężkie Jako Specyficzne Zanieczyszczenia Środowiska Wodnego; Uniwersytet Łódzki: Łódź, Poland, 2015. [Google Scholar]
- Ociepa-Kubicka, A.; Ociepa, E. Toksyczne Oddziaływanie Metali Ciężkich Na Rośliny, Zwierzęta i Ludzi. Inżynieria Ochr. Środowiska 2012, 15, 169–180. [Google Scholar]
- Giller, K.E.; Witter, E.; Mcgrath, S.P. Toxicity of Heavy Metals to Microorganisms and Microbial Processes in Agricultural Soils: A Review. Soil Biol. Biochem. 1998, 30, 1389–1414. [Google Scholar] [CrossRef]
- Ganzenko, O.; Huguenot, D.; van Hullebusch, E.D.; Esposito, G.; Oturan, M.A. Electrochemical Advanced Oxidation and Biological Processes for Wastewater Treatment: A Review of the Combined Approaches. Environ. Sci. Pollut. Res. Int. 2014, 21, 8493–8524. [Google Scholar] [CrossRef] [PubMed]
- Błaszczyk, M.K. Biologiczne Aspekty Oczyszczania Ścieków; Wydawnictwo Naukowe PWN SA: Warszawa, Poland, 2019. [Google Scholar]
- Łobos-Moysa, E.; Bodzek, M.; Śliwa, A. Wpływ Modyfikacji Kruszyw Porowatych Na Efektywność Oczyszczania Ścieków Na Złożach Biologicznych. Proc. ECOpole 2016, 10, 693–698. [Google Scholar] [CrossRef]
- Kania-Surowiec, I. Złoża Biologiczne w Oczyszczaniu Ścieków z Recyklingu Tworzyw Sztucznych. Inżynieria Ekol. 2013, 32, 74–84. [Google Scholar] [CrossRef][Green Version]
- Taherzadeh, D.; Picioreanu, C.; Horn, H. Mass Transfer Enhancement in Moving Biofilm Structures. Biophys. J. 2012, 102, 1483–1492. [Google Scholar] [CrossRef] [PubMed]
- Maurya, A.; Kumar, R.; Raj, A. Biofilm-Based Technology for Industrial Wastewater Treatment: Current Technology, Applications and Future Perspectives. World J. Microbiol. Biotechnol. 2023, 39, 112. [Google Scholar] [CrossRef] [PubMed]
- Lekang, O.-I.; Kleppe, H. Efficiency of Nitrification in Trickling Filters Using Different Filter Media. Aquac. Eng. 2000, 21, 181–199. [Google Scholar] [CrossRef]
- Rauch, B.J. Choosing a Suitable Biofilm Carrier Media. Filtr. Sep. 2014, 51, 32–34. [Google Scholar] [CrossRef]
- Boaventura, T.; Miranda Filho, K.; Oréfice, R.; Kennedy, L. Influence of Porosity of Low-Density Polyethylene Media on the Maturation Process of Biofilters Used in Recirculating Aquaculture Systems. Aquac. Int. 2018, 26, 1035–1049. [Google Scholar] [CrossRef]
- Al-Amshawee, S.; Yunus, M.Y.B.M.; Vo, D.-V.N.; Tran, N.H. Biocarriers for Biofilm Immobilization in Wastewater Treatments: A Review. Environ. Chem. Lett. 2020, 18, 1925–1945. [Google Scholar] [CrossRef]
- Derakhshan, Z.; Ghaneian, M.T.; Mahvi, A.H.; Oliveri Conti, G.; Faramarzian, M.; Dehghani, M.; Ferrante, M. A New Recycling Technique for the Waste Tires Reuse. Environ. Res. 2017, 158, 462–469. [Google Scholar] [CrossRef] [PubMed]
- Derakhshan, Z.; Ehrampoush, M.; Faramarzian, M.; Ghaneian, M.; Mahvi, A. Waste Tire Chunks as a Novel Packing Media in a Fixed-Bed Sequence Batch Reactors: Volumetric Removal Modeling. Desalin. Water Treat. 2017, 64, 40–47. [Google Scholar] [CrossRef]
- Mondal, B.; Warith, M.A. Use of Shredded Tire Chips and Tire Crumbs as Packing Media in Trickling Filter Systems for Landfill Leachate Treatment. Environ. Technol. 2008, 29, 827–836. [Google Scholar] [CrossRef] [PubMed]
- Naresh Yadav, D.; Naz, I.; Anand Kishore, K.; Saroj, D. Evaluation of Tire Derived Rubber (TDR) Fixed Biofilm Reactor (FBR) for Remediation of Methylene Blue Dye from Wastewater. Environ. Technol. 2021, 42, 3627–3640. [Google Scholar] [CrossRef] [PubMed]
- Chmielowski, K.; Halecki, W.; Masłoń, A.; Bąk, Ł.; Kalenik, M.; Spychała, M.; Niedziółka, A.; Łaciak, M.; Roman, M.; Mazurkiewicz, J. Use of Shredded Recycled Plastic as Filter Bed Packing in a Vertical Flow Filter for Onsite Wastewater Treatment Plants: Preliminary Findings. Sustainability 2023, 15, 1883. [Google Scholar] [CrossRef]
- Huan, C.; Lyu, Q.; Tong, X.; Li, H.; Zeng, Y.; Liu, Y.; Jiang, X.; Ji, G.; Xu, L.; Yan, Z. Analyses of Deodorization Performance of Mixotrophic Biotrickling Filter Reactor Using Different Industrial and Agricultural Wastes as Packing Material. J. Hazard. Mater. 2021, 420, 126608. [Google Scholar] [CrossRef] [PubMed]
- Shahryari, Z.; Fazaelipoor, M.H.; Shaabani, M.S.; Ghasemi, Y. Production of Fungal Phytase in an Innovative Trickle Bed Bioreactor. Waste Biomass Valorization 2020, 11, 3273–3280. [Google Scholar] [CrossRef]
- Guo, J. Enhancing Biological Removal of Methylene Blue from Aqueous Solutions Using Bacillus subtilis Inoculated Rice Straw. J. Environ. Eng. 2019, 145, 04018129. [Google Scholar] [CrossRef]
- Cheng, J.; Yuan, Q.; Kim, Y. Long-Term Operational Studies of Lab-Scale Pumice-Woodchip Packed Stormwater Biofilters. Environ. Technol. 2018, 39, 1765–1775. [Google Scholar] [CrossRef]
- Husein, M.; Zhao, R.-J.; Zhu, H.-D.; Xu, C.; Yang, S.; Abomohra, A.E.-F.; Kaba, P.; Yang, Q.-Z. Assessing the Performance of Modified Waste Cotton Cloth (MWCC) Installed in a Biological Contact Reactor as a Biofilm Carrier Used for Domestic Wastewater Treatment. SN Appl. Sci. 2019, 1, 1391. [Google Scholar] [CrossRef]
- Hellal, M.S.; Abou-Elela, S.I.; Aly, O.H. Potential of Using Nonwoven Polyester Fabric (NWPF) as a Packing Media in Multistage Passively Aerated Biological Filter for Municipal Wastewater Treatment. Water Environ. J. 2020, 34, 247–258. [Google Scholar] [CrossRef]
- Gopalakrishnan, M.; Punitha, V.; Saravanan, D. 8—Water Conservation in Textile Wet Processing; Muthu, S.S., Ed.; Woodhead Publishing: Cambridge, UK, 2019; pp. 135–153. ISBN 978-0-08-102633-5. [Google Scholar]
- Loo, S.-L.; Yu, E.; Hu, X. Tackling Critical Challenges in Textile Circularity: A Review on Strategies for Recycling Cellulose and Polyester from Blended Fabrics. J. Environ. Chem. Eng. 2023, 11, 110482. [Google Scholar] [CrossRef]
- Espinoza Pérez, L.A.; Espinoza Pérez, A.T.; Vásquez, Ó.C. Exploring an Alternative to the Chilean Textile Waste: A Carbon Footprint Assessment of a Textile Recycling Process. Sci. Total Environ. 2022, 830, 154542. [Google Scholar] [CrossRef] [PubMed]
- Shirvanimoghaddam, K.; Motamed, B.; Ramakrishna, S.; Naebe, M. Death by Waste: Fashion and Textile Circular Economy Case. Sci. Total Environ. 2020, 718, 137317. [Google Scholar] [CrossRef] [PubMed]
- Horn, S.; Mölsä, K.M.; Sorvari, J.; Tuovila, H.; Heikkilä, P. Environmental Sustainability Assessment of a Polyester T-Shirt—Comparison of Circularity Strategies. Sci. Total Environ. 2023, 884, 163821. [Google Scholar] [CrossRef] [PubMed]
- Moazzem, S.; Wang, L.; Daver, F.; Crossin, E. Environmental Impact of Discarded Apparel Landfilling and Recycling. Resour. Conserv. Recycl. 2021, 166, 105338. [Google Scholar] [CrossRef]
- Athanasopoulos, P.; Zabaniotou, A. Post-Consumer Textile Thermochemical Recycling to Fuels and Biocarbon: A Critical Review. Sci. Total Environ. 2022, 834, 155387. [Google Scholar] [CrossRef]
- Wu, L.; Dai, X.; Xu, J.; Ou, D.; Wang, L.; Lin, H.; He, W.; Lin, H.; Du, R.; Huang, H.; et al. Assessment of Microplastic Contamination in an Eastern Pacific tuna (Katsuwonus pelamis) and Evaluation of Its Health Risk Implication through Molecular Docking and Metabolomics Studies. Food Chem. 2023, 426, 136507. [Google Scholar] [CrossRef] [PubMed]
- Thrift, E.; Porter, A.; Galloway, T.S.; Coomber, F.G.; Mathews, F. Ingestion of Plastics by Terrestrial Small Mammals. Sci. Total Environ. 2022, 842, 156679. [Google Scholar] [CrossRef]
- Peng, C.; Zhang, X.; Li, M.; Lu, Y.; Liu, C.; Wang, L. Source Apportionment of Microplastics in Indoor Dust: Two Strategies Based on Shape and Composition. Environ. Pollut. 2023, 334, 122178. [Google Scholar] [CrossRef]
- Rajesh kumar, C.; Vidya, T.; Kanimozhi, J.; Raja, D.; Balaji, J.; Jayakumari, M.; Prakash, C. Study on Fibre Reinforced Composites Developed by Using Recycled Fibres from Garment Cut Waste. Int. J. Cloth. Sci. Technol. 2022, 34, 605–614. [Google Scholar] [CrossRef]
- Sulochani, R.M.N.; Jayasinghe, R.A.; Fernando, C.; Nilmini, A.H.L.R.; Priyadarshana, G. Life Cycle Assessment (LCA) of a Textile Waste Thermoplastic Composite Material for Wall Partitioning Applications BT—ICSBE 2022; Dissanayake, R., Mendis, P., Weerasekera, K., De Silva, S., Fernando, S., Konthesingha, C., Gajanayake, P., Eds.; Springer Nature: Singapore, 2023; pp. 441–450. [Google Scholar]
- Gedif, B.; Atalie, D. Recycling of 100% Cotton Fabric Waste to Produce Unsaturated Polyester-Based Composite for False Ceiling Board Application. Int. J. Polym. Sci. 2022, 2022, 2710000. [Google Scholar] [CrossRef]
- Yalcin-Enis, I.; Sezgin, H. Investigation of Structural Parameters of Acoustic Panels Produced from Post-Industrial Textile Wastes Containing Different Raw Materials. Prog. Rubber Plast. Recycl. Technol. 2023, 40, 121–135. [Google Scholar] [CrossRef]
- Baccouch, W.; Ghith, A.; Yalcin-Enis, I.; Sezgin, H.; Miled, W.; Legrand, X.; Faten, F. Investigation of the Mechanical, Thermal, and Acoustical Behaviors of Cotton, Polyester, and Cotton/Polyester Nonwoven Wastes Reinforced Epoxy Composites. J. Ind. Text. 2020, 51, 876–899. [Google Scholar] [CrossRef]
- Hegyi, A.; Vermeșan, H.; Lăzărescu, A.-V.; Petcu, C.; Bulacu, C. Thermal Insulation Mattresses Based on Textile Waste and Recycled Plastic Waste Fibres, Integrating Natural Fibres of Vegetable or Animal Origin. Materials 2022, 15, 1348. [Google Scholar] [CrossRef]
- Valverde, I.C.; Castilla, L.H.; Nuñez, D.F.; Rodriguez-Senín, E.; De La Mano Ferreira, R. Development of New Insulation Panels Based on Textile Recycled Fibers. Waste Biomass Valorization 2013, 4, 139–146. [Google Scholar] [CrossRef]
- Grings, K.J.; Carneiro Ribeiro, F.R.; Junior, D.V.; de Azevedo, A.R.; Kulakowski, M.P. Evaluation of Light Cementitious Matrix with Composite Textile Reinforcement from Garment Waste. Materials 2023, 16, 733. [Google Scholar] [CrossRef] [PubMed]
- Anglade, J.; Benavente, E.; Rodríguez, J.; Hinostroza, A. Use of Textile Waste as an Addition in the Elaboration of an Ecological Concrete Block. IOP Conf. Ser. Mater. Sci. Eng. 2021, 1054, 12005. [Google Scholar] [CrossRef]
- Wu, H.C.; Lim, Y.M.; Li, V.C.; Foremsky, D.J. Utilization of Recycled Fibers in Concrete. In Proceedings of the 1996 4th Materials Engineering Conference, Washington, DC, USA, 10–14 November 1996; Volume 1, pp. 799–808. [Google Scholar]
- PN-P-04604:1972; Methods of Testing Textile Raw Materials—Recognizing Fibers. Polish Standards Committee: Warsaw, Poland, 1972.
- PN-C-04550-10:1972; Water and Wastewater—Tests for Synthetic Surfactants and Their Biochemical Oxidation—Determination of Biochemical Oxidation Efficiency of Anionic and Non-Ionic Synthetic Surfactants by Activated Sludge Method under Static Conditi. Polish Standards Committee: Warsaw, Poland, 1972.
- Dębska, B.; Lichołai, L. Porównanie Wybranych Właściwości Zapraw Żywicznych Zawierających Odpadowe Tworzywa Sztuczne. J. Civ. Eng. Environ. Archit. 2016, 63, 1–23. [Google Scholar] [CrossRef][Green Version]
- EN ISO 20645:2006; Textile Fabrics. Determination of Antibacterial Activity—Agar Diffusion Plate Test. International Organization for Standardization: Geneva, Switzerland, 2006.
- EN 14119:2005 Point 10.5 (B2); Testing of Textiles. Evaluation of the Action of Microfungi. Visual Method. International Organization for Standardization: Geneva, Switzerland, 2005.
- Ramamoorthy, S.K.; Persson, A.; Skrifvars, M. Reusing Textile Waste as Reinforcements in Composites. J. Appl. Polym. Sci. 2014, 131. [Google Scholar] [CrossRef]
- Kurowski, R.; Niezgodziński, M.E. Wytrzymałość Materiałów, 8th ed.; Państwowe Wydawnictwo Naukowe: Warszawa, Poland, 1968. [Google Scholar]
- Morseletto, P. Targets for a Circular Economy. Resour. Conserv. Recycl. 2020, 153, 104553. [Google Scholar] [CrossRef]
- Setiyawan, A.S.; Nur, A.; Fauzi, M.; Oginawati, K.; Soewondo, P. Effects of Different Polymeric Materials on the Bacterial Attachment and Biofilm Formation in Anoxic Fixed-Bed Biofilm Reactors. Water Air Soil Pollut. 2023, 234, 147. [Google Scholar] [CrossRef]
- Kuszelnicka, I.; Rudawska, A.; Ginter-Kramarczyk, D.; Michałkiewicz, M.; Zajchowski, S.; Tomaszewska, J. Wpływ Zwilżalności Powierzchni Kompozytów Polimerowo-Drzewnych Na Tworzenie Biofilmu w Procesach Oczyszczania Ścieków. Polimery 2018, 63, 619–625. [Google Scholar]
- Patrick, C.; Brigitte, M.; Thierry, M.; Marie-Noëlle, B.-F.; Michel, H. Listeria Monocytogenes LO28: Surface Physicochemical Properties and Ability To Form Biofilms at Different Temperatures and Growth Phases. Appl. Environ. Microbiol. 2002, 68, 728–737. [Google Scholar] [CrossRef]
- Krzemiński, Ł.; Tański, T. Analiza Powierzchni Materiałów Porowatych. LAB Lab. Apar. Badania 2023, 6, 34–37. [Google Scholar]
- Fortuna, T.; Juszczak, L.; Matuła, D.; Wodnicka, K. Wyznaczenie Powierzchni Właściwej (S.BET) Skrobii Przy Zastosowaniu Metody Niskotemperaturowej Adsorpcji Azotu. Żywność. Technol. Jakość 1998, 14, 22–30. [Google Scholar]
- Chen, D.; Li, H.; Xue, X.; Zhang, L.; Hou, Y.; Chen, H.; Zhang, Y.; Song, Y.; Zhao, S.; Guo, J. Enhanced Simultaneous Partial Nitrification and Denitrification Performance of Aerobic Granular Sludge via Tapered Aeration in Sequencing Batch Reactor for Treating Low Strength and Low COD/TN Ratio Municipal Wastewater. Environ. Res. 2022, 209, 112743. [Google Scholar] [CrossRef] [PubMed]
- Smith, B.C. Infrared Spectroscopy of Polymers, VIII: Polyesters and the Rule of Three. Spectroscopy 2022, 37, 25–28. [Google Scholar] [CrossRef]
- Bhattacharya, S.; Chaudhari, D.S. Study on Structural, Mechanical and Functional Properties of Polyester Silica Nanocomposite Fabric. Int. J. Pure Appl. Sci. Technol. 2014, 21, 43–52. [Google Scholar]
- Billingham, J.; Breen, C.; Yarwood, J. Adsorption of Polyamine, Polyacrylic Acid and Polyethylene Glycol on Montmorillonite: An in Situ Study Using ATR-FTIR. Vib. Spectrosc. 1997, 14, 19–34. [Google Scholar] [CrossRef]
- Yin, Q.; Yang, W.; Sun, C.; Di, M. Preparation and Properties of Lignin-Epoxy Resin Composite. Bioresources 2012, 7, 5737–5748. [Google Scholar] [CrossRef]
- Sahmetlioglu, E.; Mart, H.; Yuruk, H.; Sürme, Y. Synthesis and Characterization of Oligosalicylaldehyde-Based Epoxy Resins. Chem. Pap. Slovak Acad. Sci. 2006, 60, 65–68. [Google Scholar] [CrossRef]
- Waldin, N.A.; Jamain, Z. The Effect of Alkyl Terminal Chain Length of Schiff-Based Cyclotriphosphazene Derivatives towards Epoxy Resins on Flame Retardancy and Mechanical Properties. Polymers 2023, 15, 1431. [Google Scholar] [CrossRef] [PubMed]
- Paździor, K.; Wrębiak, J.; Ledakowicz, S. Treatment of Industrial Textile Wastewater in Biological Aerated Filters—Microbial Diversity Analysis. Fibres Text. East. Eur. 2020, 28, 106–114. [Google Scholar] [CrossRef]
- Masłoń, A.; Tomaszek, J.A.; Zamorska, J.; Zdeb, M.; Piech, A.; Opaliński, I.; Jurczyk, Ł. The Impact of Powdered Keramsite on Activated Sludge and Wastewater Treatment in a Sequencing Batch Reactor. J. Environ. Manag. 2019, 237, 305–312. [Google Scholar] [CrossRef]

| Material | PES Green | PES Brown | PES Gray |
|---|---|---|---|
| Average contact angle [°] | 105.73 | 102.08 | 110.29 |
| No. | Type of Element | Type of Solution | COD after 0 Days [mg/L] | COD after 1 Day [mg/L] | COD after 6 Days [mg/L] | COD after 12 Days [mg/L] |
|---|---|---|---|---|---|---|
| 1 | not subjected to rinsing | distilled water | <15 | 106 ± 3 | 121.5 ± 0.5 | 131.5 ± 2.5 |
| 2 | rinsed once | distilled water | <15 | 18.7 ± 0.7 | 37.55 ± 3.15 | 69 ± 20.7 |
| 3 | rinsed twice | distilled water | <15 | <15 | <15 | <15 |
| Parameter | Content of Post-Flotation Wastewater in the Feed Solution [L] | Content of Post-Flotation Wastewater in the Feed Solution [%] | Conductivity [mS/cm] | pH [83,84,85] | Average COD Value [mg/L] |
|---|---|---|---|---|---|
| Model wastewater 2 | 0 | 0 | 0.885 | 7.644 | ≈400 |
| Industrial wastewater 1 | 2 | 10 | 1.336 | 9.295 | ≈380 |
| Industrial wastewater 2 | 4 | 20 | 1.864 | 9.979 | ≈349 |
| Industrial wastewater 3 | 6 | 30 | 2.36 | 10.408 | ≈384 |
| Industrial wastewater 4 | 8 | 40 | 3.20 | 10.886 | ≈490 |
| Industrial wastewater 5 | 10 | 50 | 3.97 | 11.159 | ≈534 |
| Industrial wastewater 6 | 12 | 60 | 4.94 | 11.437 | ≈458 |
Disclaimer/Publisher’s Note: The statements, opinions and data contained in all publications are solely those of the individual author(s) and contributor(s) and not of MDPI and/or the editor(s). MDPI and/or the editor(s) disclaim responsibility for any injury to people or property resulting from any ideas, methods, instructions or products referred to in the content. |
© 2024 by the authors. Licensee MDPI, Basel, Switzerland. This article is an open access article distributed under the terms and conditions of the Creative Commons Attribution (CC BY) license (https://creativecommons.org/licenses/by/4.0/).
Share and Cite
Gloc, M.; Paździor, K.; Kudzin, M.; Mrozińska, Z.; Kucińska-Król, I.; Żyłła, R. Assessment of Potential Use of a Composite Based on Polyester Textile Waste as Packing Elements of a Trickle Bed Bioreactor. Materials 2024, 17, 2028. https://doi.org/10.3390/ma17092028
Gloc M, Paździor K, Kudzin M, Mrozińska Z, Kucińska-Król I, Żyłła R. Assessment of Potential Use of a Composite Based on Polyester Textile Waste as Packing Elements of a Trickle Bed Bioreactor. Materials. 2024; 17(9):2028. https://doi.org/10.3390/ma17092028
Chicago/Turabian StyleGloc, Martyna, Katarzyna Paździor, Marcin Kudzin, Zdzisława Mrozińska, Iwona Kucińska-Król, and Renata Żyłła. 2024. "Assessment of Potential Use of a Composite Based on Polyester Textile Waste as Packing Elements of a Trickle Bed Bioreactor" Materials 17, no. 9: 2028. https://doi.org/10.3390/ma17092028
APA StyleGloc, M., Paździor, K., Kudzin, M., Mrozińska, Z., Kucińska-Król, I., & Żyłła, R. (2024). Assessment of Potential Use of a Composite Based on Polyester Textile Waste as Packing Elements of a Trickle Bed Bioreactor. Materials, 17(9), 2028. https://doi.org/10.3390/ma17092028

